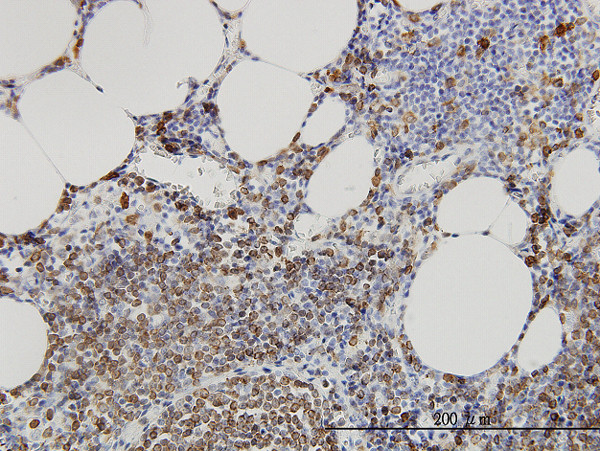
SMPD2 Antibody in Immunohistochemistry (Paraffin) (IHC (P))

Search
Abnova
SMPD2 Monoclonal Antibody (2C9)
{{$productOrderCtrl.translations['antibody.pdp.commerceCard.promotion.promotions']}}
{{$productOrderCtrl.translations['antibody.pdp.commerceCard.promotion.viewpromo']}}
{{$productOrderCtrl.translations['antibody.pdp.commerceCard.promotion.promocode']}}: {{promo.promoCode}} {{promo.promoTitle}} {{promo.promoDescription}}. {{$productOrderCtrl.translations['antibody.pdp.commerceCard.promotion.learnmore']}}
产品信息
H00006610-M01
宿主/亚型
分类
类型
克隆号
抗原
偶联物
形式
浓度
规格
保存条件
运输条件
产品详细信息
Sequence of this protein is as follows: MKPNFSLRLR IFNLNCWGIP YLSKHRADRM RRLGDFLNQE SFDLALLEEV WSEQDFQYLR QKLSPTYPAA HHFRSGIIGS GLCVFSKHPI QELTQHIYTL NGYPYMIHHG DWFSGKAVGL LVLHLSGMVL NAYVTHLHAE YNRQKDIYLA HRVAQAWELA QFIHHTSKKA DVVLLCGDLN MHPEDLGCCL LKEWTGLHDA YLETRDFKGS EEGNTMVPKN CYVSQQELKP FPFGVRIDYV LYKAVSGFYI SCKSFETTTG FDPHSGTPLS DHEALMATLF VRHSPPQQNP SSTHGPAERS PLMCVLKEAW TELGLGMAQA RWWATFASYV IGLGLLLLAL LCVLAAGGGA GEAAILLWTP SVGLVLWAGA FYLFHVQEVN GLYRAQAELQ HVLGRAREAQ DLGPEPQPAL LLGQQEGDRT KEQ
靶标信息
Converts sphingomyelin to ceramide. Hydrolyze 1-acyl-2-lyso-sn-glycero-3-phosphocholine (lyso-PC) and 1-O-alkyl-2-lyso-sn-glycero-3-phosphocholine (lyso-platelet-activating factor). The physiological substrate seems to be Lyso-PAF.
仅用于科研。不用于诊断过程。未经明确授权不得转售。